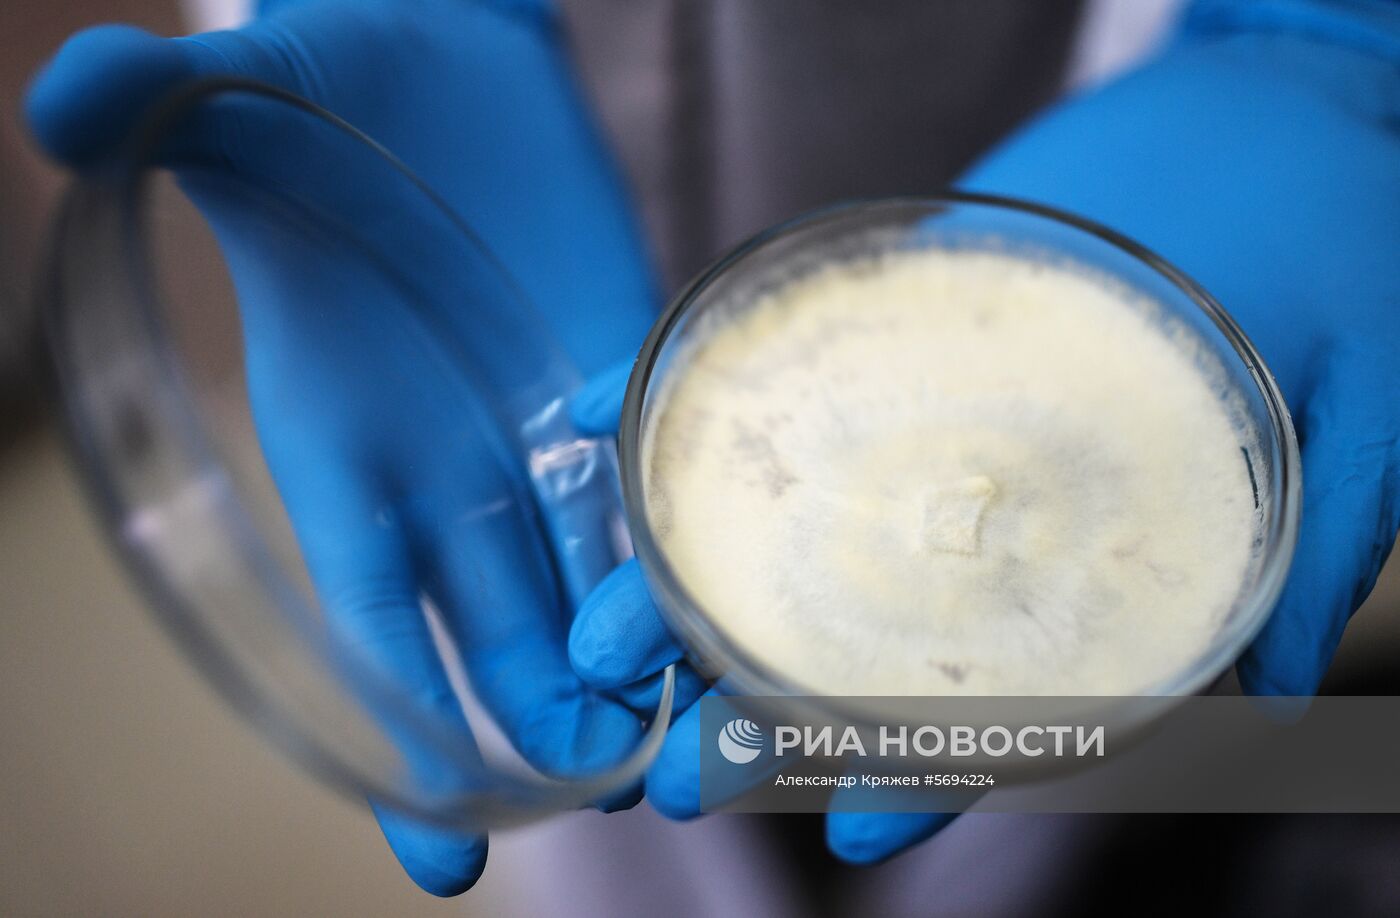
Сибирский федеральный университет в Красноярске

Чашка Петри с образцами грибов, влияющих на качество леса, в лаборатории лесной геномики Сибирского федерального университета.
- Категории: Наука и технологии, Образование
- Место: Красноярск, Россия
- Дата события: 07.11.2018
- Дата поступления: 09.11.2018
- Автор: Александр Кряжев
- Кредит: РИА Новости
- Источник: РИА Новости
- Оригинал: Цифра
- Формат: JPEG, 5012x3288px, 10.9Mb
- Job-ID: ae5dfe4ad175e3fe